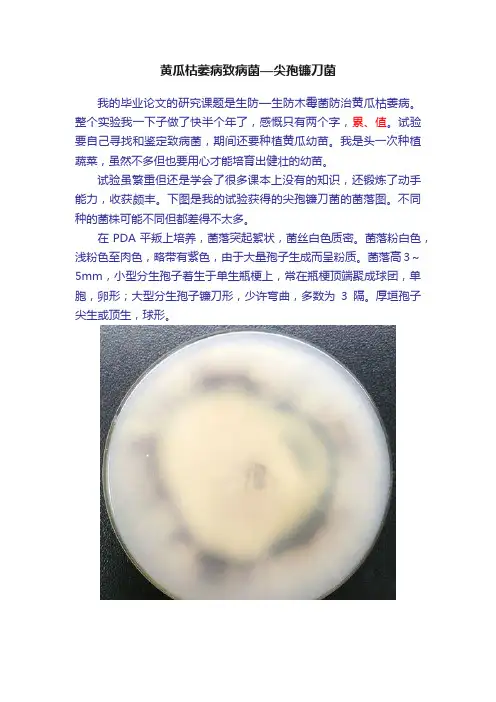

镰刀菌枯萎病
- 格式:ppt
- 大小:5.23 MB
- 文档页数:26

石家庄生物所MA-FMA-F防治香蕉巴拿马枯萎病石家庄齐凤来(050051)1香蕉枯萎病的发生历史及现状香蕉枯萎病称香蕉巴拿马病、香蕉镰刀菌枯萎病、黄叶病,是全球香蕉最重要的毁灭性土传病害之一。
该病于1874年在澳大利亚发现,1940—1950在中南美洲的巴拿马等国家的香蕉爆发感染,使风糜世界的国际贸易香蕉品种大蜜舍(Gro Michel)退出历史舞台。
1970年台湾发生香牙蕉的枯萎病,菲律宾、澳大利亚、马来西亚、非洲等国家和地区的香蕉也相继局部发生枯萎病。
法国科学家警告,香蕉巴拿马病和香蕉叶斑病有可能使种植香蕉的园地夷为平地。
我国于50—60年代在广州、广西、海南发现该病侵染为害粉蕉,1996年在广州万顷沙发生为害香牙蕉的枯萎病,由于对此病认识不足,未能采取措施控制,病害通过种苗和流水等传染途径扩散至中山、珠海、东莞、肇庆、信宜、海南等地,该病每年以30—50公里速度传播,使许多蕉园不能种植香蕉,现估计我国有10万亩蕉园受到感染,对我国香蕉种植业构成了严重的威胁2香蕉枯萎病的症香蕉黄叶病属维管束病害。
为害症状:从苗期到成株期都能染病,但只在植株将要抽蕾时症状才变得明显。
病株开始是在下层叶片及靠外的叶稍变黄色,先从叶片基部逐渐向上、或从叶缘向中脉逐渐变黄,以后整张叶片变黄、凋萎、下垂,由黄变褐色干枯。
有些叶片未变黄即下垂、或虽发黄但不下垂,有的病株是心叶坏死,基部的假茎纵裂,整株叶片均凋萎下垂。
根切开病株球茎和假茎,内部症状表现假茎和球茎维管束黄色到褐色病变,呈斑点状或线状,后期贯穿成长条形或块状部木质导管变为红棕色,一直延伸到球茎内,后来黑褐色而干枯,越近茎基部变色越深,最外层叶鞘的维管束变褐色。
病株的根系最终变黑死亡。
外部症状在龙牙蕉上表现为叶片倒垂型黄化和假茎基部开裂型黄化两种。
①叶片倒垂型黄化。
发病蕉株下部及靠外的叶鞘先出现特异性黄化,叶片黄化先在叶缘出现,后逐渐扩展到中脉,黄色部分与叶片深绿色部分形成鲜明对比。
黄瓜枯萎病致病菌—尖孢镰刀菌
我的毕业论文的研究课题是生防—生防木霉菌防治黄瓜枯萎病。
整个实验我一下子做了快半个年了,感慨只有两个字,累、值。
试验要自己寻找和鉴定致病菌,期间还要种植黄瓜幼苗。
我是头一次种植蔬菜,虽然不多但也要用心才能培育出健壮的幼苗。
试验虽繁重但还是学会了很多课本上没有的知识,还锻炼了动手能力,收获颇丰。
下图是我的试验获得的尖孢镰刀菌的菌落图。
不同种的菌株可能不同但都差得不太多。
在PDA平叛上培养,菌落突起絮状,菌丝白色质密。
菌落粉白色,浅粉色至肉色,略带有紫色,由于大量孢子生成而呈粉质。
菌落高3~5mm,小型分生孢子着生于单生瓶梗上,常在瓶梗顶端聚成球团,单胞,卵形;大型分生孢子镰刀形,少许弯曲,多数为3隔。
厚垣孢子尖生或顶生,球形。

几种罹病植物镰刀菌(Fusarium)种类鉴定前言镰刀菌无性时期在分类上原属于半知菌亚门,根据《菌物词典》2001年第9版现属于无性真菌类,有性时期为子囊菌门。
镰刀菌因其在无性阶段产生的大型分生孢子形似镰刀而称之。
镰刀菌属是在1809 年Link从锦葵科植物上发现第一株镰刀菌定名为粉红镰刀菌(Fusarium roseum Link)的基础上建立起来的[1]。
镰刀菌种类多,迄今已发现44 种和7个变种[2]。
它们分布极广,在地球上所能及的地方,几乎都能找到它的踪迹。
镰刀菌历来是真菌学和植病学的主要研究对象之一。
镰刀菌对农业生产具有重要经济意义,其中的许多种是重要的植物病原菌,往往使农作物遭受重大病害,如麦类赤霉病、棉花枯萎病、水稻恶苗病、玉米青枯病、甘薯蔓割病、瓜类枯萎病等[4],导致农业生产损失严重,甚至颗粒无收。
人类栽培的各种作物如稻、麦、棉、麻、油、茶、果树和蔬菜等,均易受到镰刀菌的侵袭而发生各种病害[4 ~ 7]。
许多重要的萎蔫病害曾在世界范围内造成许多毁灭性的植物病害。
前苏联曾有报道,当种植的甘蓝为感病品种时,镰刀菌所引起的萎蔫病害可使产量降低50%-95%。
在前苏联亚麻种植区亚麻萎蔫病发生也极为普遍,且有病的亚麻种子油是有毒的,会引起人畜中毒。
花卉植物如紫苑、石竹等等也遭受萎蔫病的损害[8],有时危害严重到需要停止栽培的地步。
除上述病害外,镰刀菌也是根腐病和各种农作物及其他植物贮存期间腐烂病的重要病原,被污染的食品和饲料含有毒质,常使人类和家畜中毒[12]。
此外,镰刀菌可引起动物病害,如镰刀菌产生的有毒代谢产物—镰刀菌毒素(Fusariotoxin)毒性很强,污染人类食品和禽畜的饲料,会造成雏鸡、鸭、鹅、鸽子、黄牛、水牛、猪、羊、马、驴等禽畜镰刀菌毒素中毒,是常见的病害。
镰刀菌作为病原微生物也能侵入人体,引起人类的真菌病。
如茄病镰孢等镰刀菌可引致人足部溃疡、眼角膜溃疡和大骨节病等。
镰刀菌产生的毒素物质可引起人和动物的急性或非急性中毒,甚至死亡。




紫花苜蓿主要病虫害苜蓿有些病害会造成幼苗死亡、产量降低或利用年限缩短,苜蓿是否会发生病害及病害的严重程度主要受气候条件、土壤类型及生产管理水平的影响。
其中,土壤排水不良是导致苜蓿发生病害最主要的原因。
苜蓿一旦发生病害,很难找到有效的措施挽回损失,所以日常管理在于防止病害的发生,而不是发生后治愈病害。
选择抗性品种是防止病害发生最经济有效的方法,因而了解苜蓿常出现的病虫害种类,对于种植苜蓿时选择针对性的抗病品种非常有益。
炭疽病炭疽病容易在湿热条件下发生,可导致苜蓿减产25%甚至以上。
感病的枝条会出现较大的卵圆形或棱形病斑,面积较大的病斑呈稻草黄色,边缘褐色(图1)。
病斑面积可能逐步扩大,最后相连环茎一周,导致植株的1个或多个枝条枯死。
感病的枝条可能迅速枯萎,看起来就像老年人的拐杖。
死亡的枯枝散落在地里,颜色呈稻草黄至珍珠白。
受感染的苜蓿根颈会变成蓝绿色,生成的新枝条很少,植株最终会死亡。
许多苜蓿品种对炭疽病都有很好或至少中等抗性。
图1 感病植株的茎上有稻黄色的病斑图2感病植株(右)根颈呈蓝绿色丝囊霉根腐病丝囊霉根腐病是潮湿土壤中最主要的一种病害,幼苗感染这种病害生长缓慢甚至死亡,成株感染后会造成根部缓慢发生病害。
受感染的幼苗子叶首先变成黄色,之后其它叶片逐渐枯黄,根部和茎部最初呈水泽状灰色,然后变成浅棕或深棕色。
幼苗停止生长,但仍然直立。
成株苜蓿感染丝囊霉根腐病后根量会减少,没有根瘤或者只有少量根瘤(图4)。
受感染植株与缺氮症状相似,越冬或刈割后再生缓慢。
最好的办法就是选择既抗丝囊霉又抗疫霉根腐病的品种。
图3感病幼苗,子叶发黄图4感染根系缺少侧根(从左侧数第2对和第4对为感病植株)丝囊霉根腐病分为1代和2代,大部分苜蓿品种对1代有抗性,但是2代会在一些地区发生,并且比1代更具破坏性。
如果种了抗性品种,但仍感染了这种病害,那就选择抗2代丝囊霉根腐病的品种。
细菌性枯萎病细菌性枯萎病在苜蓿种植后第二年、三年才开始表现,可能使种植了3到5年的苜蓿地密度严重降低。


香蕉巴拿马病的防治方法
巴拿马病又称镰刀菌枯萎病、香蕉黄叶病。
该病在我国华南地区仅危害粉蕉、龙牙蕉,有时也危害粉大蕉。
未见危害香蕉和大蕉的生理小种。
【防治方法】本病属土壤性病害。
目前还未有理想的特效药,且在我国造成危害的仅为栽种不多的粉蕉、龙牙蕉。
台湾着重于从耐病抗病品种的选育上进行防治。
(1)农业防治栽培上要选用无病苗,最好是试管苗。
于排水良好、土壤疏松的无病蕉区小面积单造种植或与高把香蕉混植。
注意排水,防止渍水烂根。
施肥要适当远离蕉头,防止断根伤根,减少病菌侵染机会。
多施木薯渣、蔗渣、石灰等改善土壤环境,使其不利于镰刀菌生长。
(2)药剂防治据印度报道,多菌灵等对预防该病和初发期使用非常有效。
其用法有3种:一是用1000ppm多菌灵淋湿根区土壤;二是在球茎中央注射3毫升2%的多菌灵液;三是种后第五、七、九个月在球茎里放入多菌灵胶囊(65毫克)。
(3)清园消毒植株发病重时要铲除病株,并注意土壤消毒,病株铲除前最好先用10~20毫升10%的草甘膦加2克多菌灵注射入离地面20~30厘米处的假茎中心,待病株死后烧毁枯干茎叶,挖除球茎,植穴用32.7%的威百亩300倍液10~20千克淋土,或用0.1%的甲氧乙基氯化汞淋土消毒,也可用棉隆或氯化苦埋入土壤,穴外未感病的植株也要用石灰等消毒。
10~20天后扒开病穴上,撤上石灰晒干
后再补种,最好补种香蕉。
发病率20%以上的蕉园应改种香蕉、大蕉或水稻等。


草坪病害的类型及症状识别实训目标通过对草坪白粉病、锈病、褐斑病、腐霉枯萎病、镰刀菌枯萎病、炭疽病、仙环病以及细菌病、病毒病等病害的症状特点和病原形态的识别,掌握上述草坪病害的症状特点及病原类型。
实训场所园林植物病理实验室。
实训形式4~6人1组,在教师指导下对供试草坪植物各种病害标本进行观察识别。
实训备品与材料按组配备双目体视显微镜、放大镜、镊子、解剖针等用具;草坪白粉病、锈病、褐斑病、腐霉枯萎病、镰刀菌枯萎病、炭疽病、仙环病以及细菌病、病毒病等草坪植物病害症状实物标本及症状类型挂图。
实训内容及方法1. 观察所有草坪草病害的挂图及幻灯片。
2. 以下列病害为代表,辨别其病状特点及病原形态(1)白粉病辨析草坪草白粉病为害状。
同时用挑取白粉及小黑点,制片镜检分生孢子、闭囊壳及附属丝。
用挑针轻轻挤压盖玻片,注意观察挤压出来的子囊及子囊孢子。
(2)锈病辨析草坪草锈病为害状。
切片或挑片镜检草坪草锈病的夏孢子及冬孢子堆。
注意辨识其形态,冬孢子双孢、有柄、壁厚;夏孢子单胞、无柄、壁薄。
(3)褐斑病辨析草坪草褐斑病为害状。
用挑针挑取菌丝镜检,观察菌丝的分枝处是否呈直角,扩大镜观察菌核的外部形态。
该病害主要结合发病现场及资料图片进行观察识别。
(4)腐霉枯萎病辨析草坪草腐霉枯萎病为害状。
用挑针挑取菌丝镜检,观察菌丝有无隔膜,能否见到姜瓣状的孢子囊,该病害主要结合发病现场及资料图片进行观察识别。
(5)镰刀菌枯萎病辨析草坪草镰刀菌枯萎病为害状。
用挑针挑取粉红色的霉层镜检,其孢子是否为镰刀形,该病害也可结合发病现场及资料图片进行观察识别。
(6)炭疽病辨析炭疽病的为害状。
该病害主要结合发病现场及资料图片进行观察识别。
(7)德氏霉叶枯病辨析该病害的为害状。
用挑针挑取霉层镜检,其分生孢子是否为长棍棒形,多分隔,该病害也可结合发病现场及资料图片进行观察识别。
(8)仙环病辨析该病害的为害状。
该病害主要结合发病现场及资料图片进行观察识别。
草坪常见病虫害近年来;作为城镇立体和庭院别墅美化中的地被植物而被广泛应用;是城市景观生态系统中的重要组成部分;也是衡量城市园林绿化水平和人均绿地面积的重要标准之一..然而;在草的生长过程中;常常会受到各种病原菌的侵染和危害;使草坪出现变色、枯死、萎蔫、腐烂等症状;从而严重影响草坪的整体观赏价值和使用价值;降低草坪质量和可用年限..因此;掌握草坪上的主要病害症状与发生规律;可以有针对性地进行防治;从而有效控制草坪主要病害的发生与危害..1草坪常见病害种类及发生特点1.1褐斑病褐斑病是所有草坪病害中分布最广的病害之一;能够侵染所有己知的草坪草;致使草坪大面积枯死..凡是在草坪能生长的地方;都会有这种病的发生与危害..染病的草坪出现大小不等的枯草圈;圈中央仍为绿色;边缘呈黄色环带;呈现‘蛙眼状”..此期间;枯草圈中心的植株可以恢复生长;但边缘的枯草则无法恢复生长..在有露水或空气湿度大的情况下;枯草圈的外缘常出现由病菌菌丝形成的“烟圈”;叶片干燥时;烟圈消失..褐斑病的病原菌为立枯丝核菌Rhizoctoniasolanf..春季;当土壤温度上升至15℃~20℃时;病菌产生大量菌丝;当气温上升至30℃左右、夜间20℃以上;且空气湿度很高时;病菌开始侵染寄主..暖季型禾草;在高温高湿条件下;病害发生发展的速度较快;草坪开始大面积发病;枯草层厚的老草坪受害较重..1.2腐霉枯萎病腐霉枯萎病又称油斑病;是草坪上毁灭性的重要病害;能够侵染所有草坪草;其中以冷季型受害最重..高温高湿的气候条件下;腐霉枯萎病能够在一夜之间毁坏大面积的草坪;使草坪突然出现直径2~5cm的圆形黄褐色枯草斑..有露水时;病叶呈水渍状;变软粘滑;有油腻感..修剪较高的草坪;枯草斑较大;修剪低的草坪;起初枯草斑较小;随后可以迅速扩大..当持续高温时;病斑会很快联合;24小时之内就能够损坏大片草坪..腐霉枯萎病的病原菌为腐霉菌Pythiumspp.;喜高温高湿..白天气温30℃以上、夜间气温高于20℃;大气相对湿度高于90%的条件下;只要维持14小时;腐霉枯萎病就会大面积发生..此病菌还可以随修剪工具传播;所以;有时会沿剪草机的作业路线;呈长条形发生..1.3夏季斑枯病夏季斑枯病又称夏季环斑病、夏季斑..是夏季高温高湿时发生在冷季型草坪上的一种严重病害;尤其在生长较密的草地草坪上;主要造成大小不等的枯斑..夏初开始表现症状;发病草坪最初出现环形小病斑;以后草坪植株变成枯黄色;出现环形枯萎病块;并逐渐扩大;直径可达40cm;最大可达80cm..在一般草坪上;病斑开始为弥散的枯黄色斑点;根部变为黑褐色;整株死亡..夏季斑枯病的病原菌;在21..C-35~C范围内均可侵染..最初;病菌只侵染根部;夏季炎热多雨、持续高温时;病害就会迅速发生;造成草坪出现大小不等的秃斑;病斑内的枯草无法恢复生长..干旱对病害影响不大..1.4镰刀菌枯萎病镰刀菌枯萎病又称蛙眼病、根腐病;可以侵染多种禾草;是草坪上普遍发生的重要病害之一..可引起根腐、叶斑、枯萎等症状;严重破坏草坪景观..草坪染病初期;呈现淡绿色小斑;不久枯黄;高温干旱条件下;形成直径2-30cm不等的、不规则形枯草斑:在适宜的温湿条件下;使草坪大面积发生叶斑..3年以上的早熟禾草坪受害后;枯草斑直径可以达到1m;边缘多为红褐色;中央草坪生长正常;四周枯死;呈“蛙眼状”;多发生在夏季湿度过高或过低时..病原菌为镰刀菌Fusariumspp.;高温干旱易引起根、茎干腐的发生;高温高湿易引起叶斑的大面积发生..1.5白绢病白绢病是由齐整小核菌Sclerotiumrolfsfi引起的一种真菌病害;主要发生在高温多雨地区;危害草坪等阔叶草..始发病时;出现直径20cm左右的圆形、半圆形枯草斑..草斑边缘枯死病株呈红褐包;枯草层上有白色绢状菌丝体和白色至褐色菌核;枯草斑中部植株仍保持绿色;呈现明显的红褐色环带;高温高湿时;病斑面积可达1m2以上..1.6云纹斑病云纹斑病是草坪上的一种常见病害之一;病原为喙孢属Rhynchosporiumspp.;主要危害叶片、叶鞘..病叶呈水渍状;叶片干枯后呈云纹状..病原菌喜冷凉环境;适宜20~C的温度..多在春季发病;秋季病害又会加重;高温干旱环境下;病害罕见发生..1.7得氏霉叶枯病得氏霉叶枯病能够侵染多种草坪禾草;引起叶斑、叶枯、根腐、茎基腐等症状;但症状随草坪草种类的不同而不同..侵染草地早熟禾时;产生水渍状小斑;后呈黄褐色;病、健交接处有黄色晕圈;病斑沿叶脉平行方向扩展;颜色由褐变白至枯黄色坏死斑;根茎受侵染后呈褐色腐烂坏死状..得氏霉叶斑病的病原;在温度20~C左右;且阴雨高湿和叶面有水滴时;最易发病..病害主要发生在春秋两季..1.8锈病锈病是草坪早熟禾上的一种重要病害;分布范围广;危害重..尤以冷季型草坪草中的、、草地早熟禾以及暖季型草坪草中的、受害最重..草坪草被侵染后呈黄色锈状;春秋两季发病重..锈病的病原菌为锈菌Pucciniaspp.;是一种严格的专性寄生菌;离开寄主就不能存活..它对湿度要求较高;但对温度的要求;因锈菌种类的不同而有差异..杆锈菌要求的温度较高;条锈菌要求的温度较低;叶锈菌则介于两者之间..2草坪常见病害的综合防治2.1选用抗病草种混播选用不同的抗病草种混合建植草坪;是防治多种草坪病害的有效措施之一..对夏季斑枯病来说;这种措施是最经济有效的方法..多年生黑麦草最抗夏季斑枯病;其次为高羊茅、匍匐翦股颖、草地早熟禾等..对腐霉枯萎病;应当以草地早熟禾为主;适当混合高羊茅、黑麦草建植草坪..锈病则应采取以草地早熟禾、多年生黑麦草和高羊茅;以7:2:1的比例混合播种.或者采取不同品种的草地早熟禾混合播种建植草坪;来防治锈病的发生与危害..2.2加强;做到科学养护1科学施肥根据草坪草习性;合理施用N、P、K肥;控制N肥的用量;增加有机肥的施用比例..重施秋肥;轻施春肥..施肥要少量勤施;平衡施肥..2合理灌溉避免大水漫灌和串灌;减少灌溉次数;控制灌水量;保持地面良好的排水功能;使草坪既不干旱;也不过湿..灌水时间最好在清晨或午后;避免在傍晚或夜间灌水..3及时修剪;清除枯草层草坪的修剪应当严格按照‘三分之一修剪”的原则;草高不超过lOcm或枯草层厚度超过2cm就要修剪..一般留草高度5-6cm;要及时清除枯草和修剪后的残留草;保持草坪清洁卫生..在高温潮湿、叶面有露水时;不宜修剪..修剪时应当先健康草坪或植株;后染病草坪或植株;以免病菌随修剪工具传播扩散..2.3合理使用药物防治药物防治就是使用化学药剂杀死或抑制病原物;防止或减轻病害的危害..化学防治作用迅速、效果显着;使用方法易于掌握;是防治草坪病害的重要手段..但它易污染和破坏生态环境;甚至还可能对草坪产生不同程度的药害..因此;应当科学合理地使用;尽量选用高效、低毒、低残留、对环境友好的药物;同时要采用先进的施药技术;减少用药量、降低残留量、减少药液的漂移..播种期和病害发生初期;是防治草坪病害的最佳时期;主要处理方法有:1药剂拌种或种子包衣处理这是防治草坪褐斑病、烂种、猝倒、腐霉枯萎病、镰刀菌枯萎病、锈病和根腐病等的有效措施之一..褐斑病可以选用草病灵2号、3号或甲基立枯灵、五氯硝基苯、粉锈宁等药剂;按种子量的0.2%-0.4%拌种或用种子包衣剂..草病灵2号、3号可以兼治夏季斑枯病、腐霉枯萎病和镰刀菌枯萎病:粉锈宁可以兼治得氏霉叶枯病、锈病和云纹斑等病害..还可以选用代森锰锌、拌种双等防治腐霉枯萎病;夏季斑枯病和镰刀菌枯萎病可选用乙膦铝、代森锰锌、甲基托布津等;锈病还可选用三唑类药剂;如三唑酮、速宝利、立克秀、羟锈宁等;按种子重量的0.2%-0.3%拌种;对病害的控制均有不同程度的作用..2播前土壤处理播前土壤处理;可以有效杀灭土壤中的各种病原菌和其他有害生物;是防治草坪病害的有效措施之一..土壤处理可以选用35%适每地水剂、32.7%斯美地水剂、98%溴甲烷气体等药剂进行;处理后需要经过10天左右才能播种;以免药剂伤害草种..2005年全球将停止使用溴甲烷;适每地和斯美地是其理想的替代品..35%适每地水剂土壤处理的方法为:处理前将土壤细碎、平整;每lOm2土壤用药剂500ml;兑水30kg;均匀浇洒在土壤上;密闭10天后揭膜;疏松表层土壤;通风透气5-7天后;平整地面;进行播种..32.7%斯美地水剂的使用方法与5%适每地水剂相似..3进行药剂防治在草坪发病初期或病害发生前;即病原菌大量侵染繁殖之前;是防治的最佳时期;应当及时选用适当药剂进行..褐斑病可选用草病灵1号、3%井冈霉素水剂或草病灵4号500-2000倍;油斑病可以选择甲霜灵、甲霜灵锰锌、乙膦铝、草病灵等500-2000倍:夏季斑可以选用草病灵、70%代森锰锌WP、70%甲基托布津WP、50%乙膦铝WP等;镰刀菌枯萎病可以选用草病灵、多菌灵、甲基托布津等;白绢病可选用50%扑海因WP1000-1500倍或64%杀毒矾WP500倍喷雾、灌根或泼浇;使用倍数视发病程度而定;一般每m2用药液量300ml以上;以保证防效;间隔期7-10天..锈病可以选用25%三唑酮粉锈宁WP1000-2000倍、12.5%速宝利特普唑WPl500倍喷雾;根腐病、云纹病可以选用25%敌力脱ec、25%粉锈宁WP、70%代森锰锌WP、50%福美双WP或25%速宝利WP等药剂稀释800-1500倍喷雾;间隔期7-10天..喷药量和喷药次数可以根据草坪草的品种、高度、植株密度以及发病情况而定..3问题、对策和展望3.1草坪病害的防治不同于其他农作物病害的防治..草坪作为城市景观的一个重要组成部分;与人们的日常生活密切相关;是人们休息、娱乐、健身等活动的重要场所..因此;在草坪病害的防治上;应当坚持健身防治措施;对草坪进行科学养护..发现病害时;合理选用适当的药剂进行防治;防治过程中;应注意防治与生态环境的关系;优先选用生物农药和高效、低毒、低残留农药;并减少农药的用量和使用次数;兼顾经济效益、社会效益和生态效益..提倡生态防治和生物防治;不污染景观和生态环境;做到既治理好草坪病害;又不影响人们对草坪的观赏和利用..3.2在草皮与草坪草种子的进口与调运过程中;应严格检疫制度;避免草坪病害病原菌的境外传入和人为远距离扩散传播与危害..3.3目前;草坪病害的防治尚处于起步阶段;与大田作物病害防治相比;还没有形成病害的预测预报和综合防治体系;在草坪病害的防治中;应做到以下几方面的工作;1加强草坪病害发生规律和防治技术的研究;2对主要病害进行系统调查与监测;有针对性地对常发病害进行及时的预测和防治指导;3加强养护人员草坪病害发生与防治知识的培训;4密切注意草坪病害的发生与危害;在发生初期及时进行科学合理的防治;5选用高效、低毒、低残留农药;避免中、高毒农药的使用..3.4在草坪病害的防治过程中;应当根据药剂的种类和特性、草坪草的敏感程度和施药时期等实际情况;选用适宜的药剂浓度和适当的施药方法;防止发生药害..一般来说;无机杀菌剂最易产生药害;有机杀菌剂和抗菌素类杀菌剂产生药害的可能性较小;而植物源杀菌剂一般不会产生药害;幼嫩组织和处于快速生长期阶段的草坪草;对药剂的敏感性高..药剂浓度越高;用药量越大;发生药害的可能性也就越大..在高温高湿环境里或敏感生育期施药时;草坪草容易发生药害..3.5植物病原物的抗药性;已经成为大田作物病害和其他植物病害防治中的一个值得注意的问题..因此;在草坪病害的防治过程中;应当及早防止草坪病害的病原物抗药性的产生..防治草坪病害可供选择的药剂种类多;作用机制复杂;药效各异;最好选用药效较好、作用方式不同的几种药剂交替使用;或者与常规广谱性杀菌剂混合使用;以抑制或减缓草坪病害抗药性的产生..例如;25%甲霜灵可湿性粉剂对卵菌纲病原菌引起的病害;如腐霉枯萎病;具有很好的防治效果;然而;甲霜灵又是一种对病原菌作用位点十分单一的药剂;多次用药后;病原菌很容易在作用位点处产生突变;大大降低甲霜灵对病原菌的治理效果;甚至完全丧失防治效果..因此;在腐霉枯萎病的药剂防治上;为防止或者减缓病原物腐霉菌抗药性的产生;提倡使用代森锰锌、甲霜灵、乙腾铝3种药剂;或者代森锰锌、杀毒矾、乙膦铝3种药剂;或者甲霜灵、杀毒矾、乙膦铝3种药剂;或者甲霜灵、杀毒矾2种药剂进行等份混合使用;既对腐霉枯萎病具有较好的防治效果;同时又可以有效防止草坪草产生抗药性。
与尖孢镰刀菌枯萎病相关的抑病型土壤研究进展尖孢镰刀菌枯萎病是一种由病原真菌引起的严重病害,可影响多种农作物的生长和产量。
针对这一问题,科研人员一直致力于寻找抑制尖孢镰刀菌枯萎病的方法,其中抑病型土壤的研究成果备受关注。
本文将探讨与尖孢镰刀菌枯萎病相关的抑病型土壤的研究进展,以期为农业生产提供有效的病害防控措施。
一、尖孢镰刀菌枯萎病概述尖孢镰刀菌是一种土壤传播的病原真菌,能够引起多种农作物的枯萎病,包括番茄、土豆、瓜类等。
尖孢镰刀菌通过土壤、种子和植株残体等途径传播,寄主范围广,传播途径多样,给农业生产带来了严重的危害。
目前,化学农药是控制尖孢镰刀菌枯萎病的主要手段,但长期大量使用化学农药不仅会造成环境污染,还会导致病原真菌对农药产生抗药性,因此急需寻找替代品和可持续的病害防控方法。
二、抑病型土壤的定义和特点抑病型土壤是指对一定病原真菌产生抑制作用的土壤类型。
抑病型土壤的形成受多种因素影响,包括土壤微生物群落结构、土壤养分状况、土壤酸碱度等。
抑病型土壤具有以下特点:1.微生物多样性高:抑病型土壤中的微生物种类丰富,包括细菌、真菌、放线菌等。
这些微生物之间存在着一定的竞争关系和协同作用,能够共同抑制病原真菌的生长和侵染。
2.土壤养分丰富:抑病型土壤中的养分含量丰富,有利于作物的生长和发育,同时也提高了作物对病原真菌的抵抗力。
3.土壤酸碱度适宜:适宜的土壤酸碱度有利于土壤中益生菌的生长和繁殖,从而抑制病原真菌的侵染。
三、抑病型土壤对尖孢镰刀菌枯萎病的防控作用针对尖孢镰刀菌枯萎病,科研人员通过大量的实验和田间观察,发现了抑病型土壤对该病害的抑制作用。
抑病型土壤在尖孢镰刀菌枯萎病的防控中发挥着重要的作用,具体表现在以下几方面:1.调节土壤微生物群落结构:抑病型土壤中的微生物群落结构丰富多样,包括一些对尖孢镰刀菌具有拮抗作用的有益微生物,如放线菌、链霉菌等。
这些有益微生物通过竞争和拮抗作用,能够有效抑制尖孢镰刀菌的生长和侵染,从而减轻病害的发生和发展。
夏季巧辨草坪褐斑病和镰刀枯萎病夏季高温高湿季节,草坪病害种类多,分布广、危害重、难识别。
特别是草坪褐斑病和镰刀枯萎病的枯草斑都会出现“蛙眼”症状,易混淆,对病害的识别会出现偏差。
区别一:病原不同,发病规律不同。
草坪褐斑病:病原菌是立枯丝核菌,属半知菌亚门无孢目丝核菌属。
是草坪寄居菌,刚被侵染后,草坪草就像刚刚被热水烫过似的,呈深绿色,在早晨有露水或湿度大时可见白色棉絮状菌丝体,这些菌丝体会自己聚集,形成白色的小颗粒,即白色的菌核,但到后期白色菌核会逐渐变成黑褐色,残留在土壤的表面。
遇到足够的水分和较高的湿度时,菌核萌发出菌丝通过雨水、灌溉水、土壤中的水的流动进行传播蔓延,病菌的菌丝首先侵染单株,破坏草坪的细胞组织,造成苗枯、根腐、叶腐、鞘腐等。
草坪镰刀枯萎病:病原菌是半知菌亚门丝孢纲瘤座孢目镰孢菌属,镰刀菌以菌丝体或厚垣孢子即休眠孢子残留在病草、病残体、土壤中越冬,当温度、湿度条件适宜时,厚垣孢子萌发出菌丝,产生大量孢子,这些不同种类的孢子,随气流、雨水、灌溉水不断进行侵染,引起草坪草苗枯、根腐、茎基腐等一系列症状。
以上两种病原菌可在土壤、植物病残体上越冬存活2年之上,周而复始,是导致病害每年频繁发生的根源,解开了养护人员对两种病害为什么每年都要发生的困惑。
区别二:症状不同。
草坪褐斑病在高温高湿的条件下,最早发病中心的草坪,根系危害较轻,出现草坪地上部死亡,留下的根出现最新的分蘖并且最早发病的病斑会逐渐的恢复,而外部草坪逐渐在危害,并且迅速在扩大。
枯草斑就出现“蛙眼”状。
即病斑中央绿色(即新萌发的新草),边缘呈枯草圈。
枯草圈直径可从几厘米到1-2米左右。
早期危害只是单株,叶鞘、叶片上产生梭形病斑(后期斑外圈是褐色,中间是灰白色),后期根部和根茎部变褐色腐烂。
镰刀枯萎病在多年的老草坪上出现,新草坪相对发生少,特别是早熟禾,在夏季湿度过高或过低时:(1)侵染单株:产生叶斑,叶斑主要生于老叶和叶鞘上,不规则形,初为水渍状墨绿色,后变枯黄色至褐色,有红褐色边缘,外缘枯黄色。